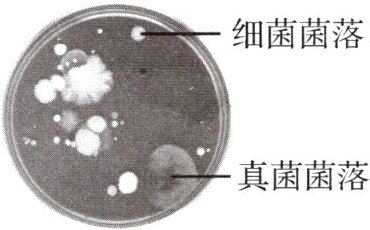

2025年金学典同步作业设计七年级生物上册人教版
注:目前有些书本章节名称可能整理的还不是很完善,但都是按照顺序排列的,请同学们按照顺序仔细查找。练习册 2025年金学典同步作业设计七年级生物上册人教版 答案主要是用来给同学们做完题方便对答案用的,请勿直接抄袭。
2. 由一个或多个细菌或真菌繁殖后形成的肉眼可见的子细胞群体被称为
菌落
。细菌的菌落比较小
(填“大”或“小”),表面或光滑黏稠,或粗糙干燥。真菌的菌落一般比较大
(填“大”或“小”)。真菌中的霉菌形成的菌落常呈绒毛状
、絮状或蜘蛛网状。真菌的菌落可呈现白、红、褐、绿、黑、黄等不同的颜色。
答案:
菌落;小;大;绒毛状
3. 培养细菌、真菌的一般方法如下。
第 1 步——配制培养基:将牛肉汁与
第 2 步——高温灭菌:配制的培养基要进行高温灭菌,杀死其中的细菌或真菌,以免影响实验,待冷却后,就可以使用。
第 3 步——接种:将少量的
第 4 步——培养:通常把接种后的培养皿放在
第 1 步——配制培养基:将牛肉汁与
琼脂
混合在一起,制成固体培养基。第 2 步——高温灭菌:配制的培养基要进行高温灭菌,杀死其中的细菌或真菌,以免影响实验,待冷却后,就可以使用。
第 3 步——接种:将少量的
细菌或真菌
转移到培养基上。第 4 步——培养:通常把接种后的培养皿放在
恒温培养箱
中恒温培养,也可以放在室内温暖的地方进行培养。
答案:
琼脂;细菌或真菌;恒温培养箱
4. 细菌和真菌是生物圈中广泛分布的生物,甚至在极端环境中也有它们的踪迹。例如,在炎热的火山口附近有可能发现
耐热
(填“耐热”或“耐寒”)细菌。
答案:
耐热
1. 下列关于微生物的叙述,错误的是(
A.微生物个体微小,结构也较为简单
B.通过显微镜可以观察到多数微生物的形态结构
C.人的身体表面、身体内部、身边环境中均有微生物存在
D.微生物都是对人的生活和健康不利的
D
)。A.微生物个体微小,结构也较为简单
B.通过显微镜可以观察到多数微生物的形态结构
C.人的身体表面、身体内部、身边环境中均有微生物存在
D.微生物都是对人的生活和健康不利的
答案:
D
2. 某同学将装有培养基的培养皿暴露在空气中一段时间后进行观察,结果如图所示。下列有关叙述错误的是(
A.空气中存在细菌、真菌等肉眼不可见的微生物
B.培养皿中的菌落是由微生物大量繁殖后形成的细胞群体
C.无法通过菌落形态、大小等特点区分细菌和真菌
D.培养基可以为细菌和真菌提供营养物质
C
)。A.空气中存在细菌、真菌等肉眼不可见的微生物
B.培养皿中的菌落是由微生物大量繁殖后形成的细胞群体
C.无法通过菌落形态、大小等特点区分细菌和真菌
D.培养基可以为细菌和真菌提供营养物质
答案:
C
3. 在冰箱中冷藏的食物更耐储存,说明微生物的生活需要(
A.充足的空气
B.适宜的温度
C.一定的水分
D.充足的阳光
B
)。A.充足的空气
B.适宜的温度
C.一定的水分
D.充足的阳光
答案:
B
4. 真菌和细菌的培养通常包括以下步骤,正确的排列顺序为(
①配制培养基 ②将培养基放在适宜的温度下培养 ③接种 ④高温灭菌
A.①②③④
B.①④③②
C.①③②④
D.①③④②
B
)。①配制培养基 ②将培养基放在适宜的温度下培养 ③接种 ④高温灭菌
A.①②③④
B.①④③②
C.①③②④
D.①③④②
答案:
B
查看更多完整答案,请扫码查看